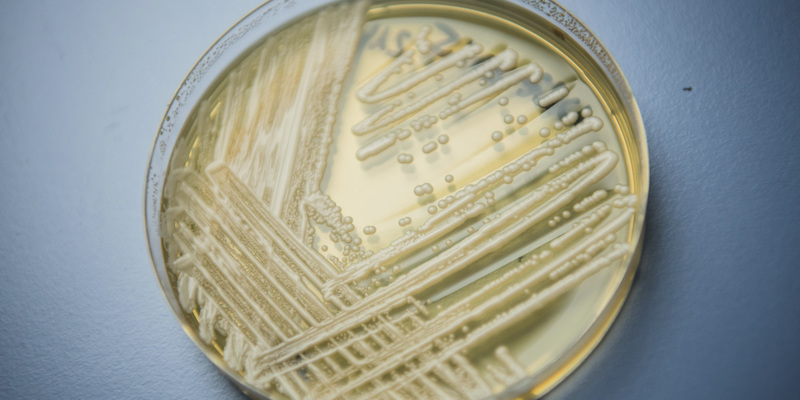

C’è una specie di Candida che non riusciamo a curare
È talmente resistente che per disinfettare completamente una stanza d'ospedale è stato necessario sostituire il pavimento e il soffitto
I progressi dell’ultimo secolo nel campo della medicina hanno completamente cambiato la qualità della vita media in gran parte del mondo: nell’Ottocento c’erano moltissimi tipi di infezioni per cui si poteva morire ancora molto giovani per mancanza di cure disponibili. La diffusione dei vaccini e degli antibiotici ha ribaltato il rapporto che abbiamo con le malattie. Tuttavia il rischio di nuove epidemie esiste e non va trascurato perché anche gli agenti patogeni – virus, batteri e funghi – evolvono e possono diventare resistenti ai farmaci che usiamo per difenderci.
Il New York Times ha dedicato un lungo articolo a uno di questi organismi, il fungo Candida auris: lo conosciamo solo da dieci anni e, anche se per ora è pericoloso solo per le persone con un sistema immunitario molto debole, è facilmente trasmissibile perché sopravvive benissimo negli ambienti per cui sono passate le persone infette. Di recente i Centers for Disease Control and Prevention (CDC), il più importante organo di controllo sulla sanità pubblica americana, l’ha aggiunta alla lista di germi considerati «minacce impellenti».
Per spiegare perché il New York Times fa un esempio abbastanza impressionante. Lo scorso maggio un uomo anziano con un’infezione da Candida auris fu ricoverato all’ospedale Mount Sinai di New York; i medici lo misero in isolamento in una stanza nel reparto di terapia intensiva. Dopo 90 giorni l’uomo morì:
Ma la C. auris no. I rilevamenti fatti nella stanza mostrarono che era dappertutto, così invasiva che l’ospedale ebbe bisogno di un’attrezzatura per le pulizie speciale per liberarsene e dovette anche rimuovere una parte del soffitto e delle piastrelle del pavimento.
«Tutto era positivo ai test: i muri, il letto, le porte, le tende, i telefoni, il lavandino, la lavagna, i pali per le flebo», ha detto il dottor Scott Lorin, presidente dell’ospedale. «Il materasso, la struttura del letto, le persiane, il soffitto, tutto quello che era nella stanza».
Cos’è la Candida auris
In breve, è un fungo che può causare infezioni pericolose nelle persone se raggiunge il sangue in circolo nel corpo. Per la precisione è un lievito del genere Candida; è lo stesso della Candida albicans, che causa la fastidiosa e diffusa candidosi vaginale sessualmente trasmissibile. Le candidosi sono le infezioni da funghi più diffuse nelle persone in degenza negli ospedali e la C. albicans è la più diffusa. I sintomi della C. auris sono più gravi in confronto: causa febbre, dolori muscolari e affaticamento. Dato che sono sintomi simili a quelli di altre malattie, tra cui l’influenza, non è facile riconoscerla.
La Candida auris è pericolosa non tanto per i suoi sintomi ma perché è resistente alla maggior parte dei farmaci contro le infezioni di funghi: secondo il CDC, più del 90 per cento delle infezioni da C. auris resistono ad almeno uno di questi farmaci (il principale è il fluconazolo); il 30 per cento resiste a due o più. Inoltre resta presente nell’ambiente in cui è stata una persona infetta a meno che non si faccia una disinfezione molto lunga e complessa, come dimostra l’esempio dell’ospedale newyorkese.
È un grosso problema, perché le persone che possono essere infettate più facilmente dalla Candida auris sono quelle con un sistema immunitario debole o indebolito, come gli anziani, i neonati (negli Stati Uniti c’è stato un caso di infezione in un reparto di neonatologia) e le persone malate. È pericolosa per i diabetici e per le persone con disturbi autoimmuni, ad esempio. Quasi la metà dei pazienti che si sono infettati con il fungo è morta entro 90 giorni, secondo i dati dei CDC, anche se non è sempre facile capire quale sia la causa della morte dato che si parla di persone con la salute già compromessa.
Da dove viene e dove si è diffusa finora
La Candida auris è stata scoperta nel 2009 in Giappone, anche se non è detto che si sia sviluppata lì: non si sa da dove venga, probabilmente si è originata in diversi posti contemporaneamente perché ci sono quattro ceppi geneticamente diversi, così diversi che probabilmente hanno iniziato a differenziarsi migliaia di anni fa. Sembra che solo di recente, e in diversi posti contemporaneamente, siano diventati resistenti agli antimicotici, cioè i farmaci contro i funghi.
Secondo molti ricercatori i ceppi resistenti agli antimicotici di Candida auris potrebbero essersi selezionati nei terreni trattati con gli azoli, gli antimicotici usati in agricoltura per evitare che le piante siano attaccate dai funghi. Usati in eccesso, avrebbero creato un ambiente così ostile ai funghi da far diffondere i pochi resistenti, facendoli prima proliferare e poi spostarsi.
In latino “auris” significa “dell’orecchio”: è stata chiamata così perché era nell’orecchio di una donna di 70 anni. Da allora è stata trovata in molti ospedali e case di cura per anziani di tutto il mondo, in particolare in India, Pakistan e Sudafrica: negli Stati Uniti ci sono stati 587 casi. Fino al 2018, quando il Centro europeo per la prevenzione e il controllo delle malattie (ECDC), che è un’agenzia dell’Unione Europea, ha diffuso una propria valutazione sui rischi legati alla C. auris, c’erano stati casi in sei paesi europei: Austria, Francia, Germania, Norvegia, Regno Unito e Spagna. Tra il 2013 e il 2017 ci sono stati 620 casi nei paesi dello Spazio economico europeo: per la stragrande maggioranza in Spagna e nel Regno Unito.
In Italia finora non se ne è parlato molto perché non ci sono stati casi noti, ma nemmeno negli altri paesi è una malattia molto conosciuta fuori dal mondo dei medici. Un po’ dipende dal fatto che ne sappiamo poco, un po’ dal fatto che gli ospedali e le istituzioni sanitarie che ci hanno avuto a che fare hanno cercato di evitare allarmismi eccessivi, anche per non compromettere la fiducia dei pazienti nei loro confronti.
Perché la C. auris potrebbe essere un grosso problema in futuro
Per ora la Candida auris è pericolosa solo per le persone con un sistema immunitario compromesso, ma gli scienziati temono che senza lo sviluppo di nuovi farmaci potrebbe diventare rischiosa anche per le persone in salute. Il fenomeno peraltro non riguarda solo questa specie, ma anche tanti altri batteri e funghi che hanno sviluppato una resistenza ai farmaci più diffusi. Oltre che sviluppare nuove cure quello che si può fare per scongiurare i rischi legati a questi nuovi germi è ridurre il ricorso ad antibiotici e antimicotici: nel 2016 durante l’Assemblea generale delle Nazioni Unite si parlò anche di questa strategia, ma da allora le cose non sono molto cambiate.
Secondo uno studio finanziato dal governo britannico, se non saranno introdotte politiche che limitino l’uso di antibiotici e antimicotici (anche negli allevamenti e nell’agricoltura) 10 milioni di persone potrebbero morire per questi nuovi germi nel 2050; per quello stesso anno si prevede che a morire di tumori saranno 8 milioni nel mondo.



